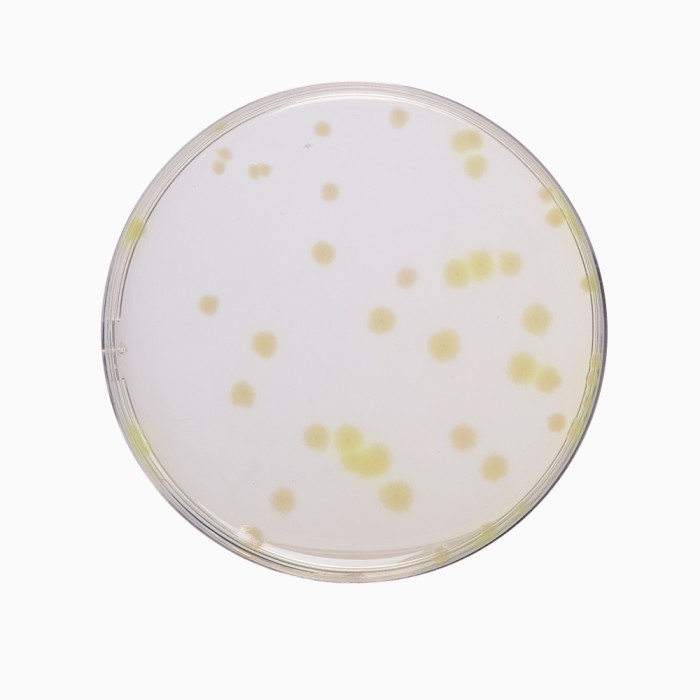
Casein Soyabean Digest Agar, Granulated  (Soyabean Casein Digest Agar, Granulated)  (Tryptone Soya Agar, Granulated)
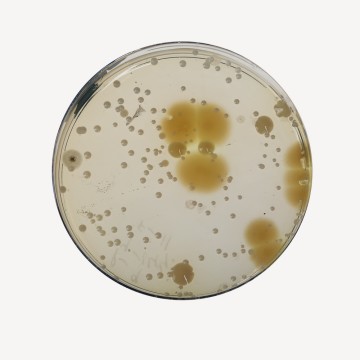
Casein-Soyabean Digest Agar, Granulated (Soybean-Casein Digest Agar, Granulated)
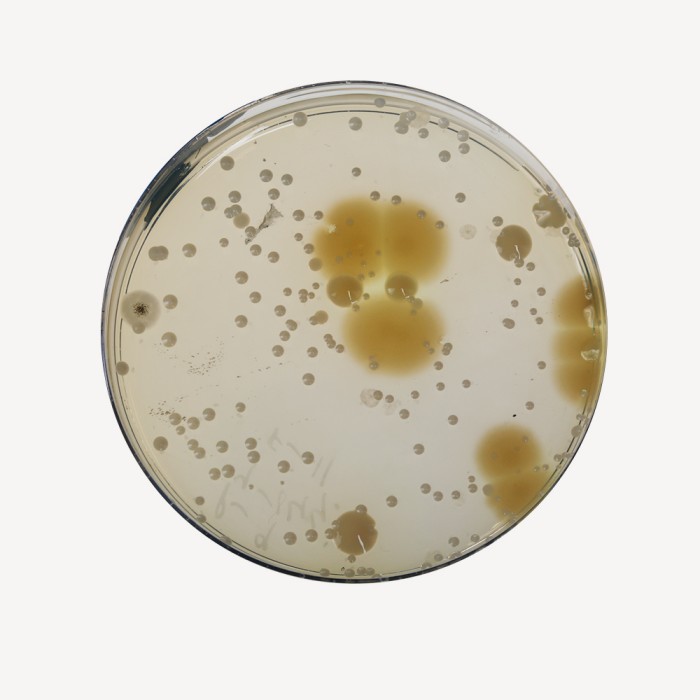
Casein-Soyabean Digest Agar, Granulated (Soybean-Casein Digest Agar, Granulated)

Your enquiry has been submitted
Casein-Soyabean Digest Agar (Soybean-Casein Digest Agar)
Intended use
Recommended as a general purpose medium used for cultivation of a wide variety of microorganisms from pharmaceutical products in accordance with harmonized method of USP/EP/BP/JP/IP (Medium 2).
Composition**
| Ingredients | g/L |
|---|---|
| Tryptone # | 15.000 |
| Soya peptone ## | 5.000 |
| Sodium chloride | 5.000 |
| Agar | 15.000 |
| pH after sterilization (at 25°C) | 7.3±0.2 |
**Formula adjusted, standardized to suit performance parameters
# Pancreatic digest of casein
##Papaic digest of soyabean (soybean)
Directions
Suspend 40.00 grams in 1000 ml purified/ distilled water. Heat to boiling to dissolve the medium completely. Sterilize by autoclaving at 15 lbs pressure (121°C) for 15 minutes or as per validated cycle. Cool to 45-50°C. Mix well and pour into sterile Petri plates.
Principle And Interpretation
Various pharmacopoeias recommend Soybean Casein Digest Agar as sterility testing medium. It is also used in validation of sterility checking procedure in accordance with the microbial limit testing harmonized methodology of USP/ EP/BP/JP/IP (1-5). This medium is used in microbial limit test and antimicrobial preservative- effective test. Gunn et al (6) used this medium for the growth of fastidious organisms and study of haemolytic reaction after addition of 5% v/v blood.
The combination of tryptone and soya peptone makes these media nutritious by providing amino acids and long chain peptides for the growth of microorganisms. Natural sugars of soy enhance growth of microorganism. Sodium chloride maintains the osmotic balance in the medium. Agar is the solidifying agent. The total aerobic count is considered to be equal to the number of colony forming units found on this medium, if colonies of fungi are detected on this medium they are counted along with total aerobic count.
Type of specimen
Pharmaceutical samples
Specimen Collection and Handling
For pharmaceutical samples, follow appropriate techniques for sample collection, processing as per pharmaceutical guidelines (1-5). After use, contaminated materials must be sterilized by autoclaving before discarding.
Warning and Precautions
Read the label before opening the container. Wear protective gloves/protective clothing/eye protection/ face protection. Follow good microbiological lab practices while handling specimens and culture. Standard precautions as per established guidelines should be followed while handling specimens. Safety guidelines may be referred in individual safety data sheets.
Limitations
- Individual organisms differ in their growth requirement and may show variable growth patterns on the medium.
- Biochemical characterization is necessary to be performed on colonies from pure cultures for further identification.
Performance and Evaluation
Performance of the medium is expected when used as per the direction on the label within the expiry period when stored at recommended temperature.
Quality Control
Appearance
Cream to yellow homogeneous free flowing powder
Gelling
Firm, comparable with 1.5% Agar gel
Colour and Clarity of prepared medium
Light yellow coloured clear to slightly opalescent gel forms in Petri plates
pH
7.10-7.50
Growth Promotion Test
Growth Promotion was carried out in accordance with the harmonized method of USP/EP/BP/JP, and growth was observed after an incubation at 30-35°C for 18-24 hours for bacteria and <=5 days in case of fungi. Recovery rate is considered 100% for bacteria growth on Soyabean Casein Digest Agar and fungus growth on Sabouraud Dextrose Agar.
Growth promoting properties
Growth of microorganism comparable to that previously obtained with previously tested and approved lot of medium occurs at the specified temperature for not more than the shortest period of time specified inoculating <=100 cfu (at 30-35°C for <=18 hours for bacteria and <=5 days for fungi). Growth of fungal cultures is also observed at 20-25°C for <=5 days.
Cultural Response
| Organism | Inoculum (CFU) | Observed Lot Recovery value (CFU) | Incubation period | Incubation temperature | |
|---|---|---|---|---|---|
| **Bacillus spizizenii ATCC 6633 (00003*) | 50-100 | 35-100 | >=70% | 18-24 hrs | 30-35 °C |
| Staphylococcus aureus subsp. aureus ATCC 25923 (00034*) | 50-100 | 35-100 | >=70% | 18-24 hrs | 30-35 °C |
| Staphylococcus aureus subsp. aureus ATCC 6538 (00032*) | 50-100 | 35-100 | >=70% | 18-24 hrs | 30-35 °C |
| Escherichia coli ATCC 25922 (00013*) | 50-100 | 35-100 | >=70% | 18-24 hrs | 30-35 °C |
| Escherichia coli ATCC 8739 (00012*) | 50-100 | 35-100 | >=70% | 18-24 hrs | 30-35 °C |
| Pseudomonas aeruginosa ATCC 27853 (00025*) | 50-100 | 35-100 | >=70% | 18-24 hrs | 30-35 °C |
| ^Pseudomonas paraeruginosa ATCC 9027 (00026*) | 50-100 | 35-100 | >=70% | 18-24 hrs | 30-35 °C |
| Salmonella Abony NCTC 6017 (00029*) | 50-100 | 35-100 | >=70% | 18-24 hrs | 30-35 °C |
| $ Kokuria rhizophila ATCC 9341 | 50-100 | 35-100 | >=70% | 18-24 hrs | 30-35 °C |
| Salmonella Typhimurium ATCC 14028 (00031*) | 50-100 | 35-100 | >=70% | 18-24 hrs | 30-35 °C |
| Candida albicans ATCC 10231 (00054*) | 50-100 | 35-100 | >=70% | <=5 d | 30-35 °C |
| Candida albicans ATCC 2091 (00055*) | 50-100 | 35-100 | >=70% | <=5 d | 30-35 °C |
| #Aspergillus brasiliensis ATCC 16404 (00053*) | 50-100 | 35-100 | >=70% | <=5 d | 30-35 °C |
| Candida albicans ATCC 10231 (00054*) | 50-100 | 35-100 | >=70% | <=5 d | 20-25 °C |
| Candida albicans ATCC 2091 (00055*) | 50-100 | 35-100 | >=70% | <=5 d | 20-25 °C |
| #Aspergillus brasiliensis ATCC 16404 (00053*) | 50-100 | 35-100 | >=70% | <=5 d | 20-25 °C |
| $$Clostridium sporogenes ATCC 19404 (00008*) | 50-100 | 35-100 | >=70% | <=48 hours | 30-35 °C |
Key
- (*) Corresponding WDCM numbers
- ^ Formerly known as Pseudomonas aeruginosa
- $ Formerly known as Micrococcus luteus
- $$ Incubated anaerobically
- ** Formerly known as Bacillus subtilis subsp. spizizenii
- # Formerly known as Aspergillus niger
Storage and Shelf Life
Store between 10-30°C in a tightly closed container and the prepared medium at 20-30°C. Use before expiry date on thelabel. On opening, product should be properly stored dry, after tightly capping the bottle in order to prevent lump formation due to the hygroscopic nature of the product. Improper storage of the product may lead to lump formation. Store in dry ventilated area protected from extremes of temperature and sources of ignition Seal the container tightly after use. Product performance is best if used within stated expiry period.
Disposal
User must ensure safe disposal by autoclaving and/or incineration of used or unusable preparations of this product. Follow established laboratory procedures in disposing of infectious materials and material that comes into contact with sample must be decontaminated and disposed of in accordance with current laboratory techniques (7,8).
| Product Name | Casein-Soyabean Digest Agar (Soybean-Casein Digest Agar) |
|---|---|
| SKU | MH290 |
| Product Type | Harmonized |
| Physical Form | Powder |
| Origin | Animal |
| Packaging type | HDPE |
| References | 1. The United States Pharmacopoeia , 2018, The United States Pharmacopoeial Convention Inc., Rockville, MD. 2.Indian Pharmacopoeia, 2018, Govt. of India, Ministry of Health and Family Welfare, New Delhi, India. 3.Gunn B. A., Ohashi D K., Gaydos C. A., Holt E. S., 1977, J. Clin. Microbiol., 5(6) : 650. 4.Forbes B. A., Sahm A. S. and Weissfeld D. F., 1998, Bailey and Scotts Diagnostic Microbiology, 10th Ed., Mosby Inc.St. Louis, Mo5.Isenberg, H.D. Clinical Microbiology Procedures Handbook. 2nd Edition. 6.Jorgensen,J.H., Pfaller , M.A., Carroll, K.C., Funke, G., Landry, M.L., Richter, S.S and Warnock., D.W. (2015)Manual of Clinical Microbiology, 11th Edition. Vol. 1. |